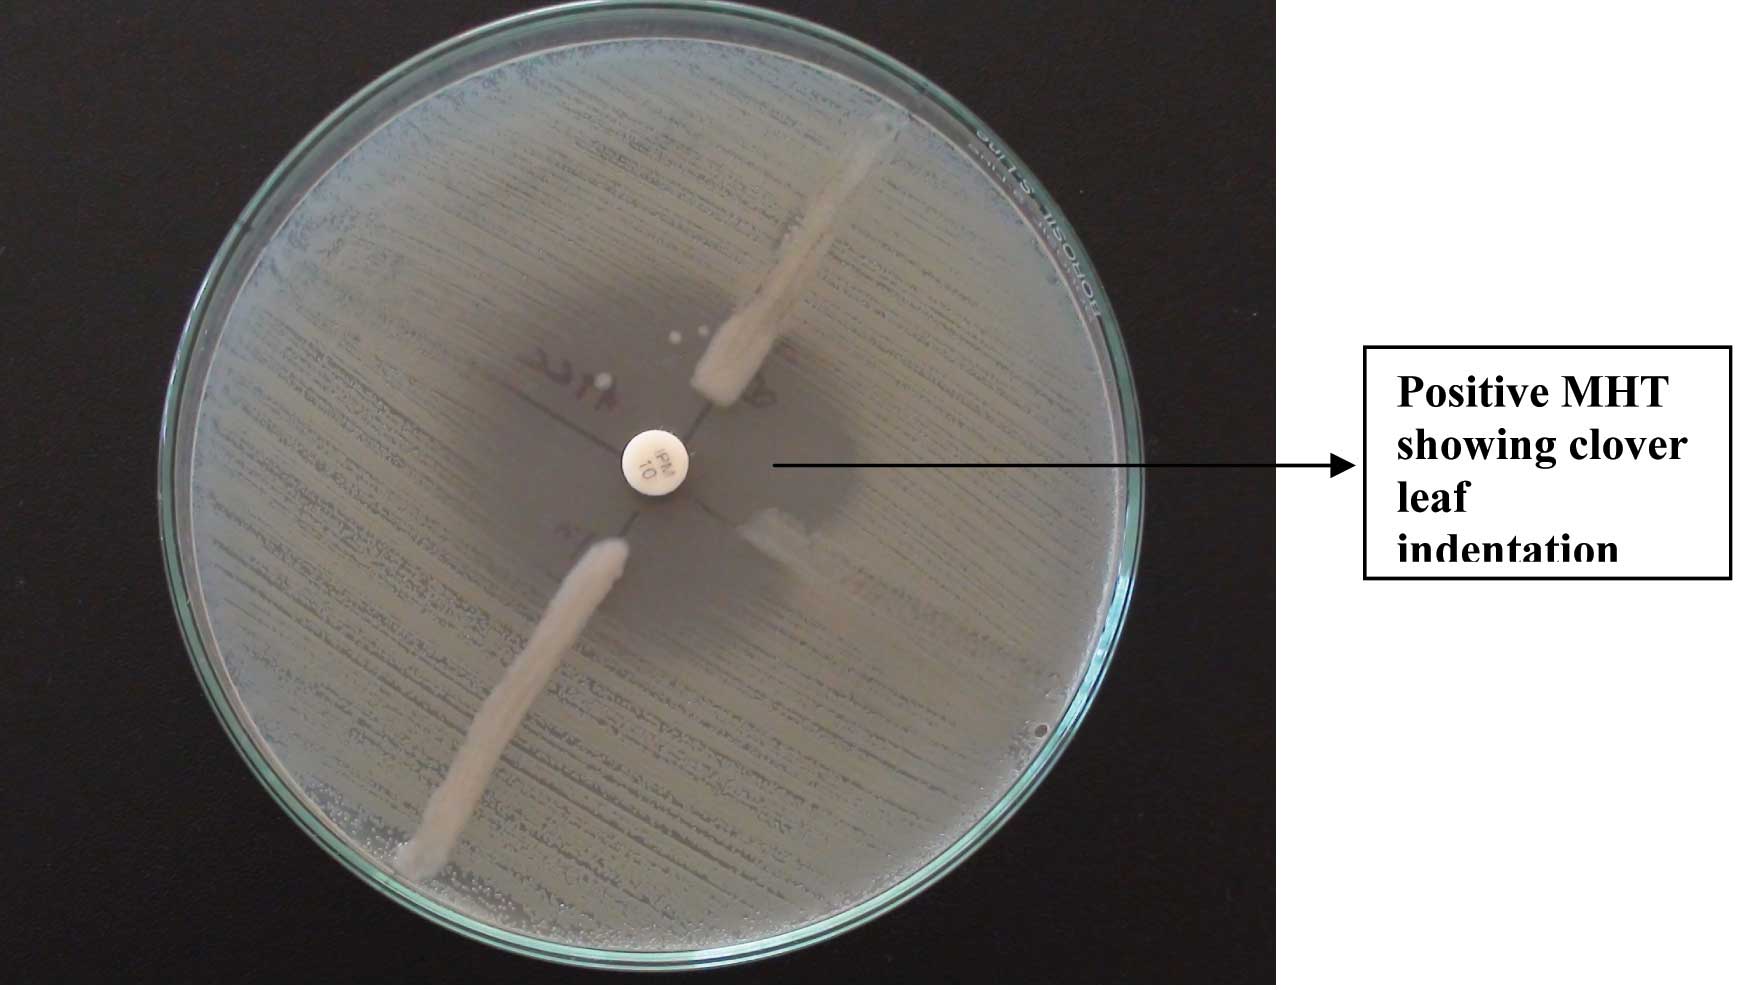

blaKPC gene Detection in Clinical Isolates of Carbapenem Resistant Enterobacteriaceae in a Tertiary Care Hospital
Priyadarshini Shanmugam1, Jeya Meenakshisundaram2, Perumal Jayaraman3
1 Associate Professor, Department of Microbiology, Chettinad Hospital and Research Institute, Rajiv Gandhi Salai, Kelambakkam, Kanchipuram, India.
2 Professor, Department of Microbiology, Chettinad Hospital and Research Institute, Rajiv Gandhi Salai, Kelambakkam, Kanchipuram, India.
3 Senior Lab Technologist, Chettinad Hospital and Research Institute, Rajiv Gandhi Salai, Kelambakkam, Kanchipuram, India.
NAME, ADDRESS, E-MAIL ID OF THE CORRESPONDING AUTHOR: Dr. Jeya Meenakshisundaram, Professor and Head, Department of Microbiology, Chettinad Hospital and Research Institute, Rajiv Gandhi Salai, Kelambakkam, Kanchipuram-603103, India.
Phone: 09688788426, 09841551891,
E-mail: drmjeya@gmail.com
Introduction: Carbapenem resistance among Enterobacteriaceae, especially in Klebsiella pneumoniae and Escherichia coli, is an emerging problem worldwide. A common mechanism of carbapenem resistance is the production of class-A, Klebsiella pneumoniae carbapenemase (KPC).
Aims and Objectives: The present study focused on determining the antibiotic resistance pattern and prevalence of bla KPC gene coding for KPC in carbapenem resistant Enterobacteriaceae.
Methodology: Forty six carbapenem resistant isolates belonging to the family Enterobacteriaceae were tested for antibiotic sensitivity pattern. Modified Hodge Test (MHT) and PCR for bla KPC gene detection were performed on these isolates. Of these, 22 were Klebsiella pneumoniae, 21 were Escherichia coli, 2 were Citrobacter species and 1 was Proteus mirabilis
Results: Forty three (93.4%) out of the 46 isolates were resistant to Meropenem, 34 (73.9%) were resistant to Imipenem and 30 (65.2%) were resistant to both Imipenem and Meropenem. Modified Hodge Test was positive in 38 (82.6%) out of 46 isolates and blaKPC gene was detected in 31 (67.4%) isolates. bla KPC gene was detected in 28 out of the 38 MHT positive isolates.
Enterbacteriaceae, Carbapenem resistance, Modified Hodge Test, blaKPC gene
Introduction
Enterobacteriaceae are a family of Gram negative bacilli which form part of normal human intestinal flora. Carbapenems belong to the beta-lactam group of antimicrobial agents, which kill bacteria by inhibiting the bacterial cell wall synthesis [1]. They possess the broadest spectrum of activity and greatest potency against Gram-positive and Gram-negative bacteria. As a result, they are often used as “last-line agents” or “antibiotics of last resort” when patients with infections become gravely ill or are suspected of harboring resistant bacteria [2]. Unfortunately, the recent emergence of multidrug-resistant (MDR) pathogens seriously threatens this class of lifesaving drugs.
Carbapenem resistance among Enterobacteriaceae, in particular among Klebsiella pneumoniae and Escherichia coli, is an emerging problem worldwide [3]. Several resistance mechanisms have been reported to circumvent the efficacy of carbapenems, and carbapenemases are the most prominent enzymes that neutralize carbapenems [3]. Carbapenemases have a breadth of spectrum unrivaled by other beta lactamases [4].
Carbapenem resistance in Enterobacteriaceae can be mediated by metalloblactamases, class A carbapenemases, or on rare occasions by OXA-type carbapenemases [5]. Other resistance mechanisms are attributed to altered affinity of PBPs for carbapenems, increased efflux of the b-lactam antibiotics, decreased permeability of the outer membrane,or to a combination of reduced permeability and high-level production of a b-lactamase, typically a class C β-lactamase [5].
A common mechanism of carbapenem resistance is the class-A, Klebsiella pneumoniae carbapenemase (KPC). In 2001, the first KPC-producing K pneumoniae isolate was reported in North Carolina. The enzyme (KPC-1) is an Ambler class A beta-lactamase [6]. KPCs have been reported in K pneumoniae and in Klebsiella oxytoca, Pseudomonas aeruginosa, Escherichia coli, Proteus mirabilis, Citrobacter freundii, Enterobacter spp, Serratia spp, and Salmonella spp. The blaKPC genes that encode KPCs are present on transferable plasmids and are flanked by transposable elements, thus allowing for the gene to move from plasmid to the bacterial chromosome and back [7]. The KPC enzyme confers resistance to all beta lactam agents including penicillins, cephalosporins, monobactams, and carbapenems [8]. In order to control the spread of blaKPC-containing bacteria in hospitalized patients, effective infection control measures and controlled antibiotic usage must be complemented by the utilization of rapid and sensitive bla KPC diagnostic assay [1].
The present study focused on determining the antibiotic resistance pattern and prevalence of bla KPC gene in Carbapenem Resistant Enterobacteriaceae.
Material and Methods
The study was conducted in Clinical Microbiology Lab at Chettinad Hospital and Research Institute, Chennai, for a period of 1 year. All Enterobacteriaceae isolates from clinical samples like pus, wound swab, sputum, endotracheal aspirate, blood and urine were screened for Carbapenem resistance. Antibiotic susceptibility testing was performed for these isolates by Kirby Bauer method, as per the CLSI guidelines 2012. Antimicrobial discs used were Ampicillin (20μg), Gentamicin (10μg), Amikacin (30μg), Cefazolin (30 μg), Cefuroxime (30μg) Ceftazidime (30μg), Cefotaxime (30μg), Ceftriaxone (30μg), Cefepime (30μg), Ciprofloxacin (5μg), Cotrimoxaole (1.25 μg/23.75 μg), Piperacillin/tazobactam (100/10μg), Imipenem (10μg), Meropenem (10 μg), Polymyxin B (300 units) and Colistin (10μg). The institutional ethical committee approval was obtained prior to commencement of this study.
46 isolates of Enteobacteriaceae, which were resistant to either Imipenem or Meropenem or both, were selected for further testing by Modified Hodge Test and blaKPC gene detection.
Modified Hodge Test
Carbapenemase production was detected by using the Modified Hodge test. This test was performed as per the CLSI guidelines 2012. A 0.5 Mac Farland’s suspension of ATCC Escherichia coli 25922 was diluted 1:10 in sterile saline. This was inoculated on a Mueller Hinton agar plate, as for the routine disc diffusion testing. The plate was dried for 5 minutes and a disc of Imipenem 10 μg was placed in the centre of the agar plate. 3-5 colonies of the test organism were picked and inoculated in a straight line, from the edge of the disc, upto a distance of at least 20mm. The plates were incubated at 370C overnight and they were examined next day. They were checked for an enhanced growth around the test organism, at the intersection of the streak and for a zone of inhibition. The presence of an enhanced growth indicated carbapenemase production, and the absence of an enhanced growth meant that the test isolate did not produce carbapenemase [9].
blaKPC gene Detection
DNA Extraction: The isolates to be tested were inoculated into sterile nutrient broth. After overnight incubation, the broth was transferred to sterile Eppendorf vials and centrifuged at 10000 RPM for 10 minutes. The supernatant was discarded while the pellet was used for the blaKPC gene detection.
The pellet was suspended in 200μl of PBS and 50μl of Lysozyme was added and incubated at 37°C for 15min. Then 400μl of Lysis buffer and 40μl of proteinase K (10mg/ml) were added and gently mixed well. This was incubated in water bath at 70°C for 10 min. The whole lysate was transferred into Pure Fast spin column and centrifuged at 10000 rpm for 1min. The flow through was discarded and 500μl of Wash Buffer was added and centrifuged at 10000 rpm for 1 min. The wash procedure was repeated one more time. The flow through was discarded and the column was centrifuged for additional 2 minutes to remove any residual ethanol. DNA was eluted by adding 100μl of Elution Buffer and it was centrifuged for 1min. 1μl of extracted DNA was used for PCR amplification.
PCR Procedure
The Polymerase Chain Reaction was set up in a PCR vial, after adding the master mix, the forward and reverse primers and the extracted DNA. 25μl of Master Mix contained 10X Taq buffer, 2mM Mgcl2, 0.4mM dNTPs mix, and 2U Proofreading Taq DNA polymerase. The primers used were
Forward Primer: 5’-GCT CAG GCG CAA CTG TAA G-3’
Reverse Primer: 5’-AGC ACA GCG GCA GCA AGA AAG-3’
The PCR vial was placed in PCR machine and it was subjected to initial denaturation at 94°C for 3 min, followed by 30 cycles of denaturation at 94°C for 1 minute, annealing at 60°C for 1minute and extension at 72°C for 1minute. A final extension procedure was carried out at 72° C for 5 min. Gel electrophoresis was then carried out using 2% agarose gel. Gel was viewed in a UV Transilluminator and the bands pattern was observed.
Results
Forty six isolates belonging to the family Enterobacteriaceae were tested. Of these, 22 were Klebsiella pneumoniae, 21 were Escherichia coli, 2 were Citrobacter species and 1 was Proteus mirabilis [Table/Fig-1]. These isolates were from pus, urine, blood, sputum and endotracheal aspirates. Of the 46 isolates, 43 (93.48%) were resistant to meropenem, 34 (73.91%) were resistant to imipenem and 30 (65.21%) were resistant to both imipenem and meropenem. Modified Hodge Test was positive in 38 (82.6 %) out of 46 isolates and blaKPC gene was detected in 31 (67.4%) isolates.
Identification of the isolates & their carbapenem sensitivity

The results of Modified Hodge Test (MHT) and PCR for bla KPC gene detection are tabulated in [Table/Fig-2]. The antibiotic resistance pattern of the isolates is tabulated in [Table/Fig-3]. Among the 30 isolates which were resistant to both imipenem and meropenem, MHT was positive in 27 isolates (90%) and negative in 3 (10%) isolates. Twenty one (77.7%) of the 27 MHT positive isolates were found to be having the blaKPC gene while the remaining 6 isolates were negative for the gene. Of the 3 MHT negative isolates, one was positive for bla KPC gene. Three isolates were resistant to imipenem and sensitive to meropenem. Two of these isolates were MHT positive and one was MHT negative. bla KPC gene was detected in one of the MHT positive isolates. One isolate which was resistant to imipenem and Intermediate to meropenem, gave a positive result with the MHT and for the bla KPC gene detection.
Results of MHT and bla KPC gene detection

Antibiotic resistance pattern of the Multi Drug Resistant isolates
| Percentage of Resistance | Klebsiella (n =22) | Escherichia coli (n =21) | Citrobacter (n =2 ) | Proteus (n = 1) |
|---|
| Ampicillin | 100% | 100% | 100% | 100% |
| Cotrimoxazole | 100% | 100% | 100% | 100% |
| Gentamicin | 73% | 67% | 100% | 100% |
| Tobramycin | 94% | 73% | 100% | 100% |
| Amikacin | 59% | 33% | 100% | 100% |
| Nitrofurantoin (urine) | 100% | 20% | 100% | 100% |
| Ciprofloxacin | 91% | 91% | 100% | 100% |
| Cefazolin | 100% | 100% | 100% | 100% |
| Cefuroxime | 100% | 100% | 100% | 100% |
| Cefotaxime | 100% | 100% | 100% | 100% |
| Cefipime | 96% | 100% | 100% | 100% |
| Piperacillin Tazobactam | 100% | 100% | 100% | 100% |
| Imipenem | 77% | 67% | 100% | 100% |
| Meropenem | 96% | 95% | 50% | 100% |
| Polymixin B | 0% | 0% | 0% | 100% |
| Colistin | 0% | 5% | 0% | 100% |
Twelve isolates were imipenem sensitive, but meropenem resistant. MHT was positive in 8 (66.6%) of these isolates. Of this only 5 (41.7%) were blaKPC positive, while 3 were negative for the gene. MHT was negative in the remaining 4, of which 2 each tested to be bla KPC gene positive and negative respectively. [Table/Fig-4] shows an isolate which is MHT positive and [Table/Fig-5] shows the positive and negative PCR results for the bla KPC gene.
PCR for bla KPC gene – Gel Electrophoresis

Discussion
In this study carbapenem resistance was seen mainly among Klebsiella species, followed closely by Escherichia coli [Table/Fig-1]. The majority of the carbapenem resistant isolates were from urine (39.2%), followed by pus 34.7 %, respiratory 13% and blood 8.6%. This correlates with the findings of Nagaraj et al., [1] who have reported 42% isolates from urine, followed by 18% from wound infections.
All the carbapenem resistant isolates showed 100% resistance to ampicillin, cotrimoxazole, all 4 generations of cephalosporins and piperacillin tazobactam [Table/Fig-3]. The resistance to aminoglycoside antibiotics varied from 33% for amikacin to 94% to tobramycin [Table/Fig-3]. In the present study, Klebsiella showed a 77% resistance to imipenem and 96% resistance to meropenem, while E coli showed 67% resistance to imipenem and 95% resistance to meropenem. A study by Francis RO et al., [10] showed that among the samples that were confirmed positive for carbapenem resistance, the rate of resistance for each organism was 29% for Klebsiella pneumoniae, 2.8% for Escherichia coli and 3% for Enterobacter spp.
Modified Hodge Test [Table/Fig-2] was positive in 38 (82%) out of 46 isolates and blaKPC gene was detected in 31 (67.4%) isolates. PCR was positive in 28 (73.7%) out of 38 MHT positive isolates and negative in 5 (62.5%) out of the 8 MHT negative isolates. A study by Mosca A et al., in Italy showed that 84% of the carbapenem resistant strains evaluated by MHT showed the production of carbapenemase and that PCR for bla KPC gene showed a 100% positivity [11] Another study by Ragunathan A et al., [7] showed that PCR assay for blaKPC gene was positive in 82% of the MHT positive test isolates and was negative in 87% of the MHT negative isolates. The MHT results of the present study correlate with the findings of the other 2 studies. The present study showed blaKPC gene prevalence of 67.4 % among the carbapenem resistant Enterobacteriaceae. United States-wide surveillance study estimated the prevalence of blaKPC among various Enterobacteriaceae was 0.5%, whereas a study of Brooklyn hospitals reported 38% prevalence in K. pneumoniae [12]. Another study by Deshpande et al., reports a positivity rate for blaKPC gene as 44 out of 51 Carbapenem resistant isolates [13].
Of the 3 MHT negative isolates, one was positive for bla KPC gene. Cabral AB et al., [14] have also reported such isolates carrying silent genes. 8 (17.3%) isolates were resistant to carbapenems, but were MHT negative. They may have developed a different resistant mechanism other than carbapenemase production.
bla KPC gene was not detected in 10 MHT positive isolates. This indicates the presence of a carbapenemase other than KP Carbapenemase. Resistant to both imipenem and meropenem is a strong indicator of carbapenemase production rather than resistance to either one of the carbapenems, as this may imply a different resistance mechanism.
Conclusion
The prevalence of carbapenem resistance is increasing at a rapid pace. Carbapenem resistance by the KPC production is the most common mechanism as evidenced by MHT and PCR. Timely intervention in the form of rapid detection, good infection control practices and judicious use of antibiotics will ensure that the spread of drug resistance among bacteria is kept under control.
[1]. Nagaraj S, Chandran SP, Shamanna P, Macaden R, Carbapenem resistance among Escherichia coli and Klebsiella pneumoniae in a tertiary care hospital in south IndiaIndian J. Med. Microbiol 2012 30(1):93-95. [Google Scholar]
[2]. Krisztina M, Wallace P, Endimiani A, Taracila MA, Bonomo RA, Minireview Carbapenems: Past, Present, and FutureAntimicrob. Agents Chemother Nov. 2011 55(11):4943-60. [Google Scholar]
[3]. Hindiyeh M, Smollen G, Grossman Z, Ram D, Davidson Y, Mileguir F, Rapid Detection of blaKPC Carbapenemase Genes by Real-Time PCRJ Clin Microbiol Sept. 2008 46(9):2879-83. [Google Scholar]
[4]. Queenan AM, Bush K, Carbapenemases: the versatile β-LactamasesClin Microbiol Rev 2007 July 20(3):440-58. [Google Scholar]
[5]. Rasmussen JW, Høiby N, Class A carbapenemasesJ Antimicrob Chemother 2007 60:470-82. [Google Scholar]
[6]. Ryan S A, Kerri A T, Sharma S, Phillips M, Johnson JK, Daniel JM, Emergence of Klebsiella Pneumoniae Carbapenemase-producing BacteriaSouth Med J 2011 104(1):40-45. [Google Scholar]
[7]. Raghunathan A, Samuel L, Tibbetts RJ, Evaluation of a Real-Time PCR Assay for the Detection of the Klebsiella pneumoniae Carbapenemase Genes in Microbiological Samples in Comparison With the Modified Hodge TestAm J Clin Pathol 2011 135:566-71. [Google Scholar]
[8]. Anderson KF, Lonsway DR, Rasheed J K, Biddle J, Jensen B, McDougal LK, Evaluation of Methods To Identify the Klebsiella pneumoniae Carbapenemase in EnterobacteriaceaeJ Clin Microbiol Aug. 2007 45(8):2723-25. [Google Scholar]
[9]. The Clinical and Laboratory Standards Institute. Performance Standards for Antimicrobial Susceptibility testing, twenty second informational supplement, M100-S22, Clinical and Laboratory Standards Institute. 2012 [Google Scholar]
[10]. Francis RO, Wu F, Phyllis DL, Shi J, Whittier S, Rapid Detection of Klebsiella pneumoniae Carbapenemase Genes in Enterobacteriaceae Directly From Blood Culture Bottles by Real-Time PCRAm J Clin Pathol 2012 137(4):627-32. [Google Scholar]
[11]. Mosca A, Miragliotta L, Prete RD, Tzakis G, Dalfino L, Bruno F, Rapid and sensitive detection of blaKPC gene in clinical isolates of Klebsiella pneumoniae by a molecular real-time assaySpringer Plus 2013 2:31 [Google Scholar]
[12]. Marschall J, Tibbetts RJ, Michael Jr WM, Frye JG, Fraser VJ, Warren DK, Presence of the KPC Carbapenemase Gene in Enterobacteriaceae Causing Bacteremia and Its Correlation with In Vitro Carbapenem SusceptibilityJ. Clin. Microbiol January 2009 47(1):239-41. [Google Scholar]
[13]. Deshpande LM, Rhomberg PR, Sader HS, Jones RN, Emergence of serine carbapenemases (KPC and SME) among clinical strains of Enterobacteriaceae isolated in the United States Medical Centers: Report from the MYSTIC Program (1999–2005)Diagn Microbiol Infect Dis December 2006 56(4):367-72. [Google Scholar]
[14]. Cabral AB, Melo RCA, Maciel AMV, Lopes ACS, Multidrug resistant gene, including bla KPC and bla CTX-M-2 among Klebsiella pneumoniae isolated in Recife, BrazilRev Soc Bras Med Trop Sep-Oct, 2012 45(5):572-78. [Google Scholar]